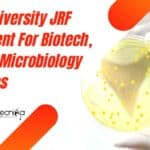
Panjab University JRF Recruitment

Home Search
physics - search results
If you're not happy with the results, please do another search
IISc MSc Programme Admission 2023-24 For MSc Life Sciences
IISc MSc Admission 2023-24 For MSc Life Sciences Programme
IISc MSc Admission 2023-24 For MSc Life Sciences Programme - New Launch. IISc has several new...
Biotecnika Times Newsletter 06.02.2023 SURE Internships 2023 With Fellowships, Lilly Interns
Biotecnika Times Newsletter 06.02.2023 SURE Internships 2023 With Fellowships, Lilly Interns
Summer Undergraduate Research Exposure (SURE) Internships 2023 at IIT Hyderabad With Rs. 15,000 pm...
MSc Project-JRF Job For Life Sciences Candidates at RCB – Apply Online
MSc Project-JRF Job For Life Sciences Candidates at RCB - Apply Online
MSc Project-JRF Job For Life Sciences Candidates at RCB - Apply Online. MSc...
Biotecnika Times Newsletter 02.02.2023 BARC OCES-2023 and DGFS-2023 Notification
Biotecnika Times Newsletter 02.02.2023 BARC OCES-2023 and DGFS-2023 Notification
BARC OCES-2023 and DGFS-2023 Notification - DAE-Training Schools Scientific Officers Recruitment 2023
BARC OCES-2023 and DGFS-2023 Notification...
Panjab University JRF Recruitment For Biotech, Biochem, Microbiology Candidates
Panjab University JRF Recruitment For Biotech, Biochem, Microbiology Candidates
Panjab University JRF Recruitment For Biotech, Biochem, Microbiology Candidates. Candidates with MSc in Biophysics/Biochemistry/Microbiology/ Biotechnology qualifications can...
BARC OCES-2023 and DGFS-2023 Notification – DAE-Training Schools Scientific Officers Recruitment 2023
BARC OCES-2023 and DGFS-2023 Notification - DAE-Training Schools Scientific Officers Recruitment 2023
BARC OCES-2023 and DGFS-2023 Notification - DAE-Training Schools Scientific Officers Recruitment 2023. BARC...
UPSC IFS Exam 2023 – Indian Forest Service Exam 2023 Application, Eligibility
UPSC IFS Exam 2023 - Indian Forest Service Exam 2023 Application, Eligibility
The application is Open now for UPSC Indian Forest Service Exam – preliminary...
Visiting Students’ Research Programme (VSRP-2023) – Summer Research Programme With Monthly Stipend
TIFR Hyderabad Summer Research Programme - Visiting Students' Research Programme (VSRP-2023)
TIFR Hyderabad Summer Research Programme - Visiting Students' Research Programme (VSRP-2023). TIFR Hyderabad Semester...
CBMR Research Associate Jobs For PhD Biotech, Life Sciences, Biology, Biochemistry
CBMR Research Associate Jobs For PhD Biotech, Life Sciences, Biology, Biochemistry
CBMR Research Associate Jobs For PhD Biotech, Life Sciences, Biology, Biochemistry. Centre of Biomedical...
IISER Pune PhD Admissions 2023 (August) – Biology PhD Programme
IISER Pune PhD 2023 Admissions (August) - Biology PhD Programme
IISER Pune PhD 2023 Admissions (August) - Biology PhD Programme. IISER Pune PhD Admission. IISER...
14 Openings at DRDO-INMAS – BSc Candidates Apply For Graduate Apprentice Vacancies
DRDO-INMAS Graduate Apprentice Recruitment For BSc Biology
DRDO-INMAS Graduate Apprentice Recruitment For BSc Biology. Apply online for graduate apprentice jobs at DRDO - INMAS. DRDO...
Govt of India, Dept. of Space NESAC Life Sciences Jobs – 18 Openings Available
NESAC Life Sciences Jobs at Dept. of Space - Attend the Walk-In
NESAC Life Sciences Jobs at Dept. of Space - Attend the Walk-In. Govt...
IIT Indore BSBE PhD Admission Program 2023 – Applications Invited
IIT Indore PhD Admission Program 2023 - Applications Invited
IIT Indore BSBE PhD Admission Program 2023 - Applications Invited. IIT Indore PhD Admission 2023. Department...
DRDO-DIPAS Hiring To Work In Futuristic Research Projects As JRFs, Attend Walk-In
DRDO-DIPAS Project JRF Jobs For MSc, MTech Life Sciences
DRDO-DIPAS Project JRF Jobs For MSc, MTech Life Sciences. Walk-In-Interview at DRDO - Defence Institute of...
Jubilant Biosys Structural Biology Research Scientist Job Opening, Apply Online
Jubilant Biosys Structural Biology Research Scientist Job Opening, Apply Online
Jubilant Biosys Structural Biology Research Scientist Job Opening, Apply Online. Jubilant Biosys Limited jobs 2023....